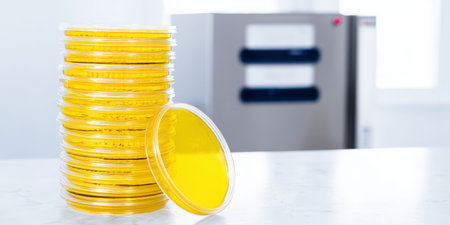
Petri dishes stacked and standing with yellow agar medium in a lab setting, sharp foreground of culture plates against a blurred incubator and equipment for microbiology testing and researchの素材

素材 - Petri dishes stacked and standing with yellow agar medium in a lab setting, sharp foreground of culture plates against a blurred incubator and equipment for microbiology testing and research
作品情報
Petri dishes stacked and standing with yellow agar medium in a lab setting, sharp foreground of culture plates against a blurred incubator and equipment for microbiology testing and research
- ID:254879710
- 作品種別:
- 作者名:Olga Khelmitskaya
キーワード
- agar
- analysis
- bacteria culture
- biochemistry
- biological
- biology
- biotechnology
- chemical
- chemist
- culture
- developing
- development
- diagnosis
- discovery
- education
- equipment
- experiment
- growth medium
- health
- healthcare
- innovation
- lab
- laboratory
- medical
- medicine
- microbiology
- petri dish
- pharmaceutical
- research
- sample
- science
- scientific
- scientist
- sterile
- sterile environment
- studying
- technology
- testing
- vaccine
- virus
類似作品
Stack of colour...
stacked plates,...
stacks of color...
Clean dishes in...
Stack of white ...
shiny restauran...
drying dishes w...
Stacks of Clean...
Plates layer on...
White storage s...
Pile of clean p...
Disappointed mi...
Close up of pla...
Rows and stacks...
Stack of white ...
porcelain plate...
White plates on...
Plates are neat...
porcelain plate...
A vibrant colle...
A kitchen count...
A stack of whit...
Wooden crockery...
a lot of white ...
Bowls were stac...
Stacks of many ...
a lot of white ...
lots of dirty w...
Lots of dirty d...
Close-up shot h...
Empty plate
Disk pottery at...
Various moulds ...
washed dishes i...
many empty whit...
Rustic wooden s...
Work surface an...
Close-up view o...
Close up stack ...
Ceramic plates ...
Bright orange d...
A dishwasher wi...
Vintage cupboar...
group of white ...
Rows of upside ...
Group of white ...
Stack of white ...
Group of white ...